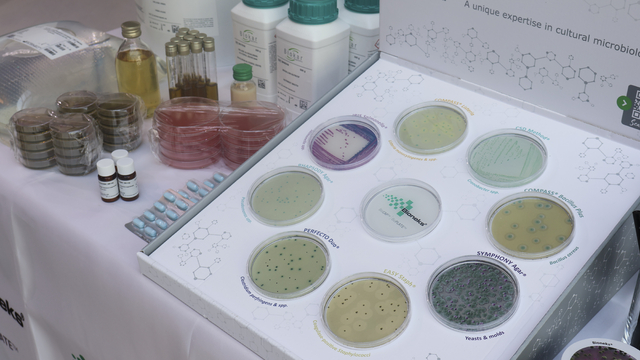
Galeri

Süt sektöründeki gelişmeler 3. Ulusal Sütçülük Kongresi'nde masaya yatırılıyor
3. Ulusal Sütçülük Kongresi Başkanı Prof. Dr. Barbaros Özer, süt sektöründeki küçük üreticilerin etkin bir örgütlenme modeli içinde bir araya getirilmesi ve markalaşmalarının önündeki engellerin kaldırılması gerektiğini bildirdi.

3. Ulusal Sütçülük Kongresi Başkanı Prof. Dr. Barbaros Özer, süt sektöründeki küçük üreticilerin etkin bir örgütlenme modeli içinde bir araya getirilmesi ve markalaşmalarının önündeki engellerin kaldırılması gerektiğini bildirdi.
Ankara Üniversitesi Ziraat Fakültesi Süt Teknolojisi Bölümü ve Süt Akademisi ortaklığıyla düzenlenen 3. Ulusal Sütçülük Kongresi, Cer Modern'de başladı.
Özer, kongrenin açılışında yaptığı konuşmada, bu yılki etkinliğin ana temasının "sürdürülebilirlik" olduğunu ve "Sürdürülebilirlik perspektifinden süt endüstrisinin geleceği" konusunun bütün detaylarıyla ele alınacağını söyledi.
Türkiye'nin, üretim gücü yüksek bir ülke olduğunu dile getiren Özer, bu güce rağmen hala üretilen sütün kontrol altına alınamadığını anlattı.
Özer, sütçülükte bir kalite sorunu yaşandığını ve bunun aşılamadığını ifade ederek, bu yıl başlatılan süte protein ve yağ üzerinden kalite teşviki verme uygulamasının, sorunu aşmada yetersiz olduğunu savundu.
Sütün, yağ ve protein içeriğinin özel sektör tarafından değerlendirilen bir konu olduğunu vurgulayan Özer, halkın sağlığını ve güvenliğini koruma refleksinin bir teşvike dönüştürülmesi için sütteki somatik hücre sayısına, antibiyotiğe ve toplam bakteri sayısına odaklanılmasının daha yerinde olacağını kaydetti.
Sütçülükte yüzde 70 düzeyinde süt üreticisinin, 10 başın altında hayvan sayısına sahip olduğuna dikkati çeken Özer, "Söz konusu küçük üreticilerin etkin bir örgütlenme modeli içinde bir araya getirilmesi ve markalaşmalarının önündeki engellerin kaldırılması gerekiyor." dedi.
- Dünya genelinde 150 milyon hane halkı süt üretimi yapıyor
Birleşmiş Milletler Gıda ve Tarım Örgütü (FAO) Orta Asya Alt Bölge Koordinatörü ve Türkiye Temsilcisi Viorel Gutu da dünya genelinde 6 milyardan fazla insanın süt ve süt ürünleri tükettiğini bildirdi.
Bu insanların çoğunun gelişmekte olan ülkelerde yaşadığını belirten Gutu, şöyle konuştu:
"Geçtiğimiz 30 yıl içinde süt üretimi yüzde 59'dan fazla artış gösterdi. Öyle ki 1988'de 330 milyon ton olan süt üretimi, 2018'de 843 milyon tona yükseldi. Küresel süt üretiminde Hindistan yüzde 22'lik dilimle başı çeken ülke. Bugün dünya genelinde 150 milyon hane halkı süt üretimiyle iştigal ediyor."
Gutu, FAO'nun süt endüstrisinin geliştirilmesi için ortaya koyulan tüm çabaları desteklemeye devam edeceğini ifade ederek, Türkiye'de hükümetin süt üreticilerini desteklemek ve sektörün modernizasyonunu sağlamak için pek çok politikayı benimsediğini ve yürüttüğünü vurguladı.
Etkinlik kapsamında yarın da 3 oturum gerçekleştirilecek.
Anadolu Ajansı, DHA ve İHA tarafından geçilen tüm Ankara haberleri, bu bölümde Haberturk.com editörlerinin hiçbir editoryal müdahalesi olmadan otomatik olarak ajans kanallarından geldiği şekliyle yer almaktadır. Ankara Haberleri alanında yer alan haberlerin hepsinin hukuki muhatabı haberi geçen ajanslardır.